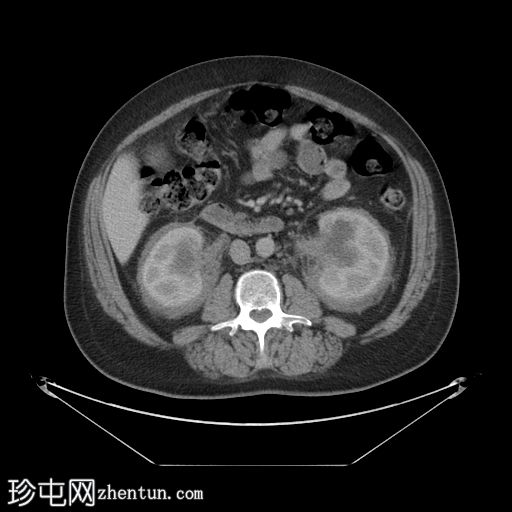
1.jpg

临床表现
患者主诉上腹部疼痛1天。炎症指标升高。体格检查发现右侧腹部压痛,右髂窝有肌紧张,考虑阑尾炎。
患者资料
年龄:50岁
性别:男
CT
轴位增强扫描(门静脉期)

冠状位增强扫描(门静脉期)

矢状位增强扫描(门静脉期)
肾周可见重度、相对均匀的浸润,呈“毛肾征”。肾积水,但无输尿管积水。
肝、脾、胰腺和肾上腺正常。胆囊正常,无胆管扩张。
小肠和大肠(包括阑尾)未进行肠道准备,均正常。
未见其他异常。
组织病理学报告
左肾下极周围活检:
纤维血管和脂肪组织核心,其中一个核心边缘可见少量炎症性肾皮质组织。
广泛的纤维化和局灶性脂肪坏死;部分区域背景水肿,伴有中度慢性炎症,包括少量淋巴细胞聚集和浆细胞簇,散在分布着肥大细胞。梭形细胞增生,细胞形态良性,并散在分布着泡沫状组织细胞。未见恶性肿瘤证据。免疫组化染色显示梭形细胞为组织细胞:CD68 和 CD163 阳性,因子 XIIIa 强表达,S100 呈局灶性染色。CD1a 和 Braf 染色基本阴性。
简要基因检测报告:M117.1,BRAF c.1799T>A p.(Val600Glu) V600E 致病热点变异,手动检测到,变异水平极低(3.5% VAF)。
结果符合 Erdheim-Chester 病。
病例讨论
本病例的肾脏表现具有独特性,几乎是 Erdheim-Chester 病的特征性表现。然而,如果某些疾病的症状不太明显,则需要注意与之相似的疾病,例如淋巴瘤。 |